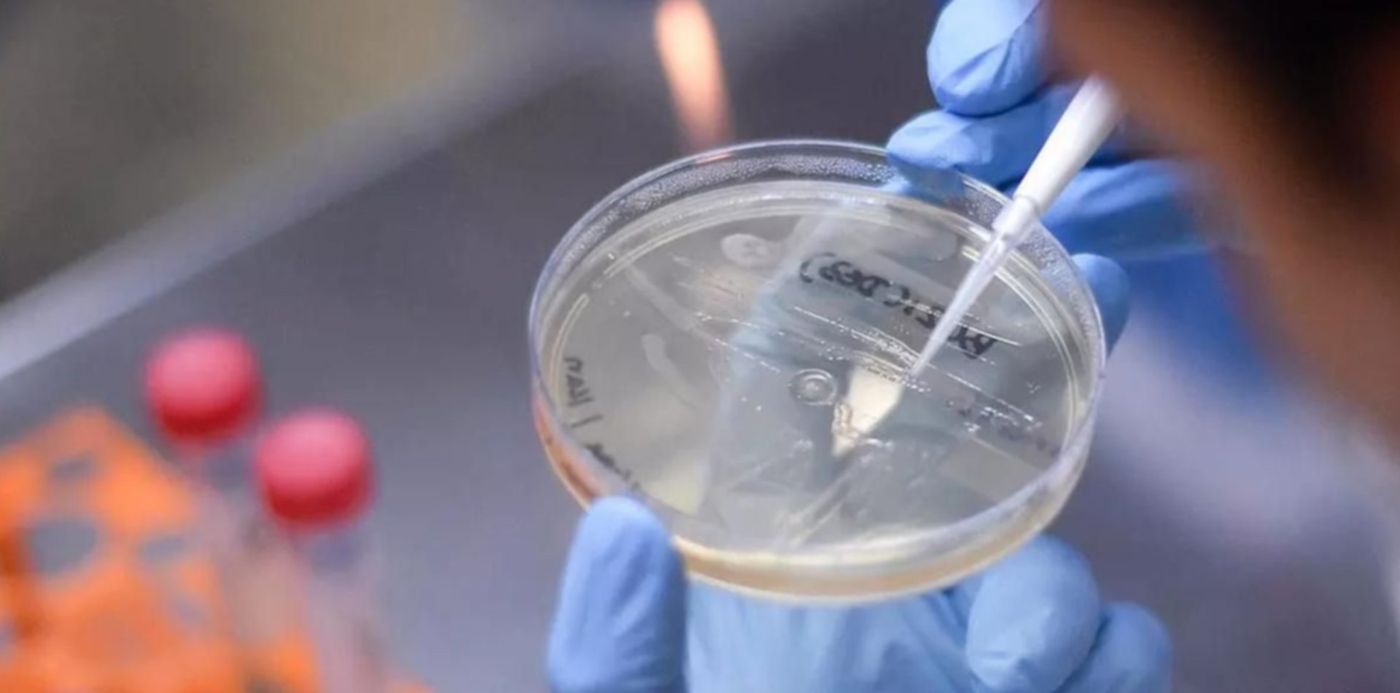
1624303272186.jpg?x=11&y=133&width=1184&height=592&rotate=0&scaleX=1&scaleY=1&ow=1200&oh=800&&cw=1920&ch=950

El Ministerio de Salud de la Ciudad de Buenos Aires investiga dos posibles casos de personas que se infectaron de COVID-19 con la variante Delta, que no registran antecedes de viajes al exterior y que tampoco tendrían ahora nexo epidemiológico con nadie que haya estado fuera de la Argentina. Las autoridades están trabajando para determinar si son contagios por transmisión comunitaria del virus.
El hecho fue confirmado en las últimas horas por fuentes del gobierno porteño y se da en marco de una creciente preocupación por ralentizar el ingreso al país de la variante más contagiosa del coronavirus.
En caso de que no se comprueben los contactos estrechos con viajeros recientemente regresados a la Argentina, la situación podría confirmar que existe circulación comunitaria de la variante Delta en Capital Federal. Sin embargo, los especialistas esperan precisiones para confirmar la información.
Hasta el 23 de julio, el Gobierno había identificado en el país un total acumulado de 46 secuenciaciones genómicas de esta variante de preocupación: 45 pertenecían a personas con antecedente de viaje internacional y uno es un caso con nexo epidemiológico con un viajero.

Este jueves, en tanto, en Córdoba se detectó que un hombre que volvió de viaje con el virus no cumplió la cuarentena y estuvo en contacto con familiares no convivientes. A raíz de esta situación, se registraron 17 casos positivos con la variante Delta.
Las autoridades de esa provincia implementaron una intensa búsqueda de todas las personas que mantuvieron contacto con el primer portador de la variante. En una carrera contrarreloj se busca ahora detectar y aislar a todos los contactos estrechos antes de que el virus logre la circulación comunitaria. La situación obligó a aislar 160 personas y hay cinco colegios con burbujas afectadas por estos contactos.